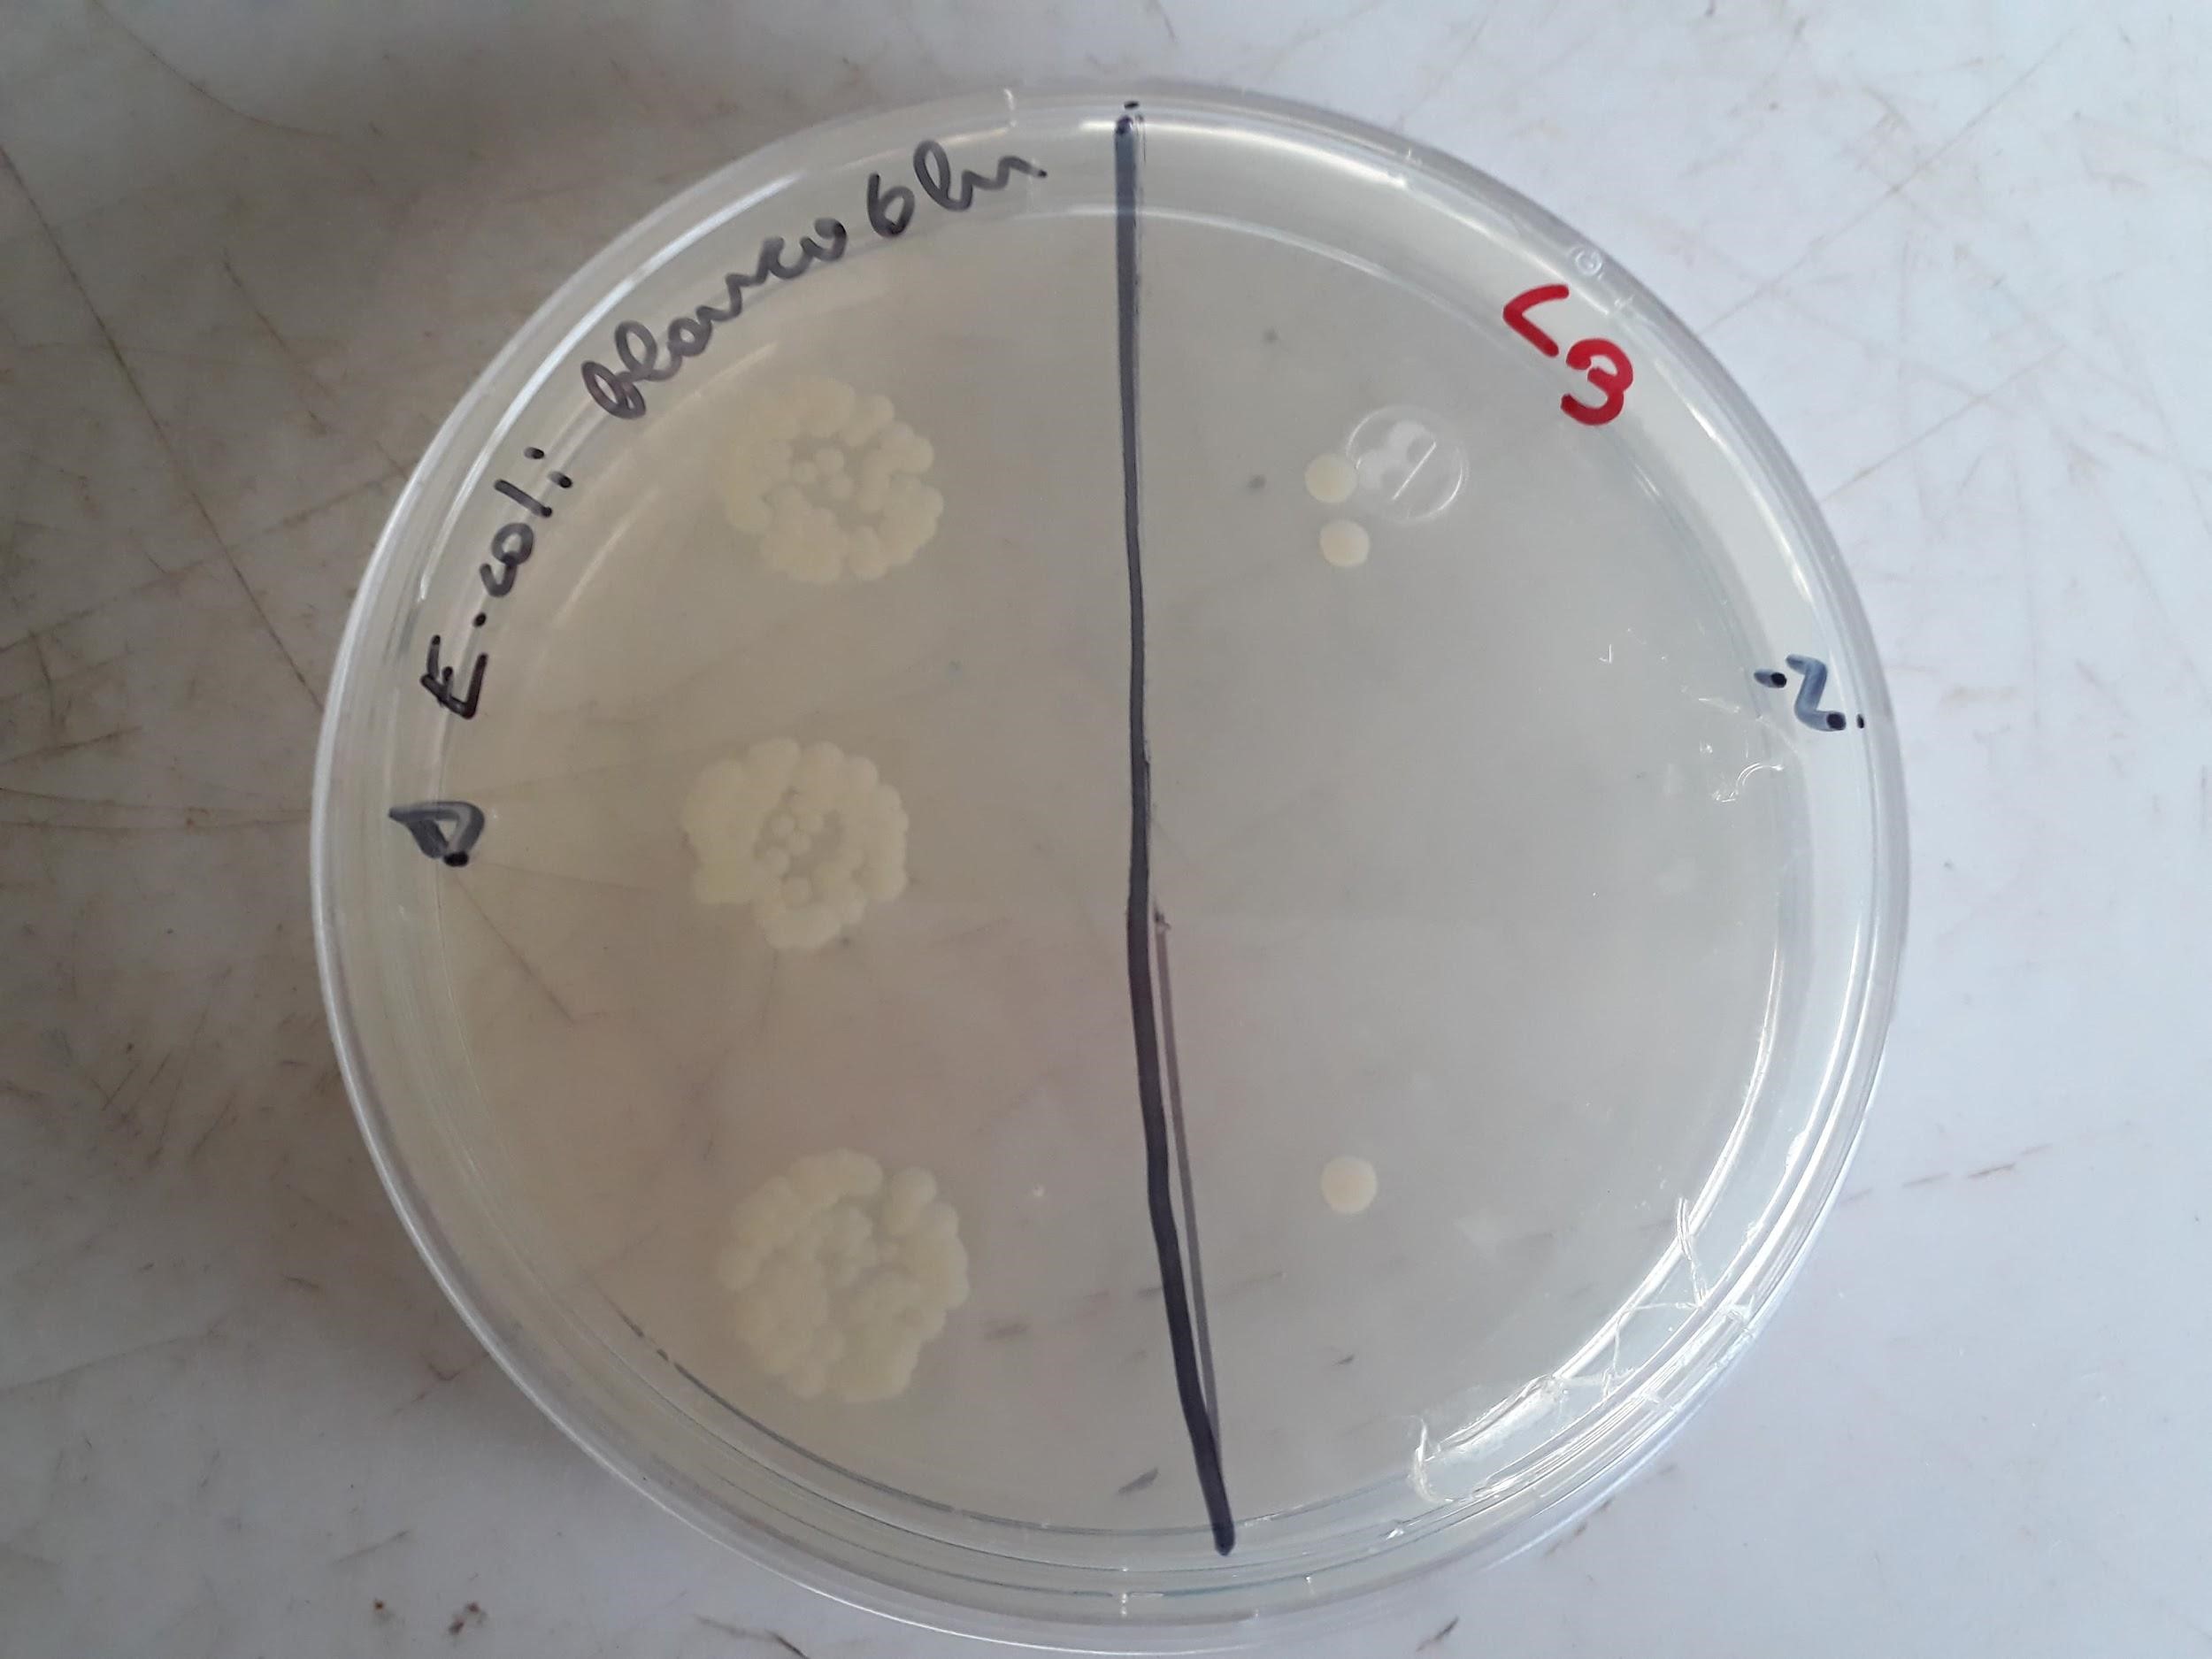

Asistencia Técnica
SERVICIO DE PREPARACIÓN DE MUESTRAS HISTOLOGICAS DE ORIGEN ANIMAL Y VEGETAL
El servicio incluye:

 Procesamiento de la muestra.
Procesamiento de la muestra.
- Cortes histológicos.
- Muestra de referencia con tinción de Hematoxilina-Eosina (muestra de origen animal) o Verde rápido-safranina (muestras de origen vegetal).
*Adicionalmente, se puede solicitar otras tinciones que estén disponibles en el Laboratorio.
Para información de valores y dudas contactarse con:
Claudia Ojeda: claudia.ojeda@pucv.cl, teléfono: +56 32 2274834
Paulina Schmitt: paulina.schmitt@pucv.cl, teléfono +56 32-2274868
ASISTENCIA TÉCNICA LABORATORIO DE NEMATOLOGÍA
El servicio incluye:
- Servicio de análisis nematológico.
- Investigación y desarrollo de productos biológicos y químicos con actividad nematicida:
- Estudio en condiciones de laboratorio
- Estudio en condiciones de invernadero
- Estudio en condiciones de campo
Para información de valores y dudas contactarse con:
Juan Carlos Magunacelaya: juan.magunacelaya@pucv.cl, teléfono: +56 32 274856
SERVICIOS DE MICROBIOLOGIA

- Identificación de microorganismos (Secuenciación 16S RNA, BIOLOG)
- Determinación de capacidades metabólicas de comunidades microbianas
- Determinación de actividad antimicrobiana en muestras y superficies.
- Determinación de carga y diversidad microbiana.
Para informaciones de valores y dudas contactarse con:
Carolina Yáñez: carolina.yañez@pucv.cl, teléfono: +56 32 2274867
SERVICIO DE INMUNOLOGIA

- Producción de anticuerpos policlonales en ratones.
- Evaluación de estatus inmune en peces salmónidos.
- Análisis in vitro de biomoléculas e inmunomoduladores en líneas celulares de peces salmónidos

- Ensayos de ELISA para citoquinas pro-inflamatorias en muestras de peces salmónidos.
- Análisis de inmunofluorescencia en microscopía
- confocal de moléculas y marcadores de superficie en peces salmónidos.
Para informaciones de valores y dudas contactarse con:
Luis Mercado Vianco: luis.mercado@pucv.cl, teléfono: +56 32 2274860
